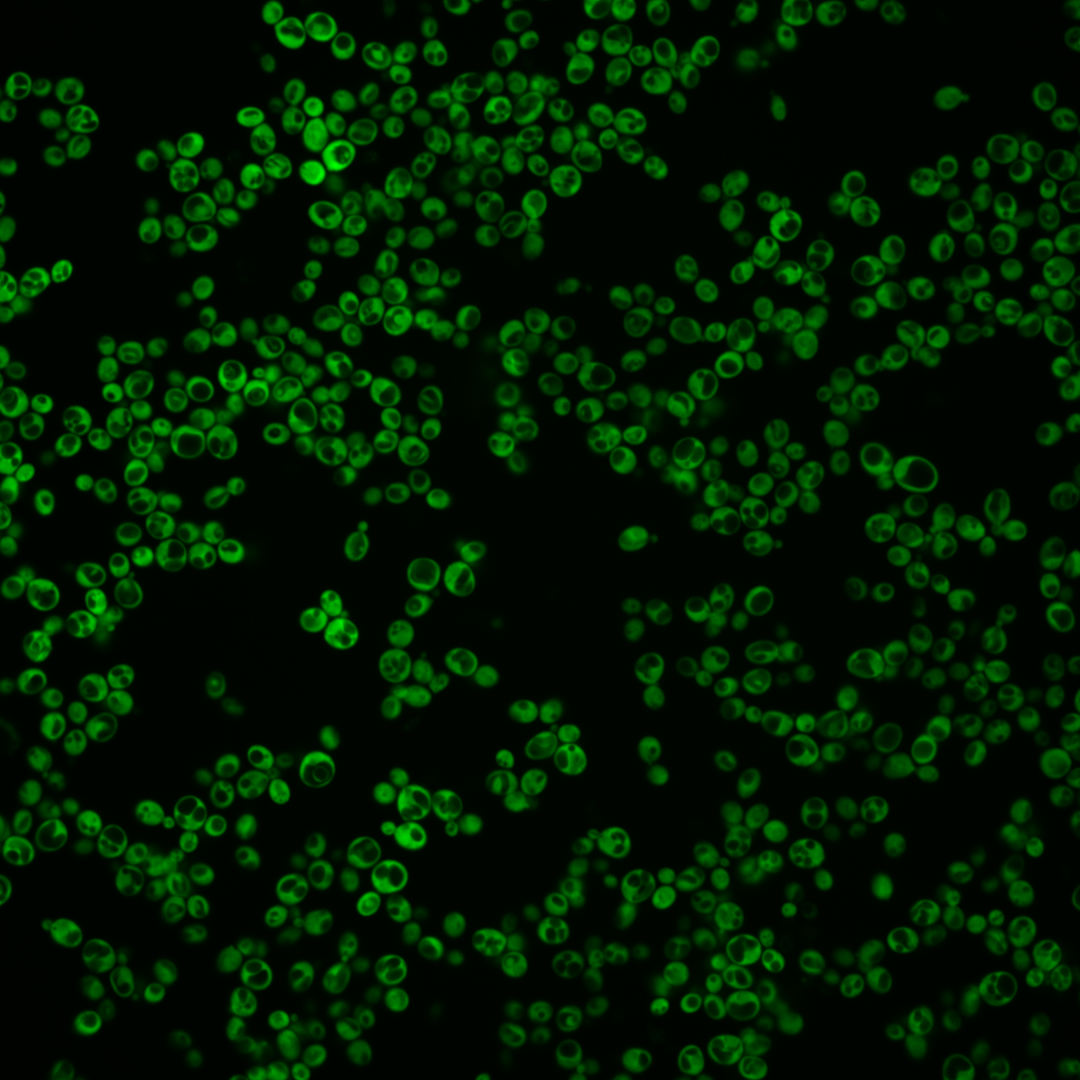
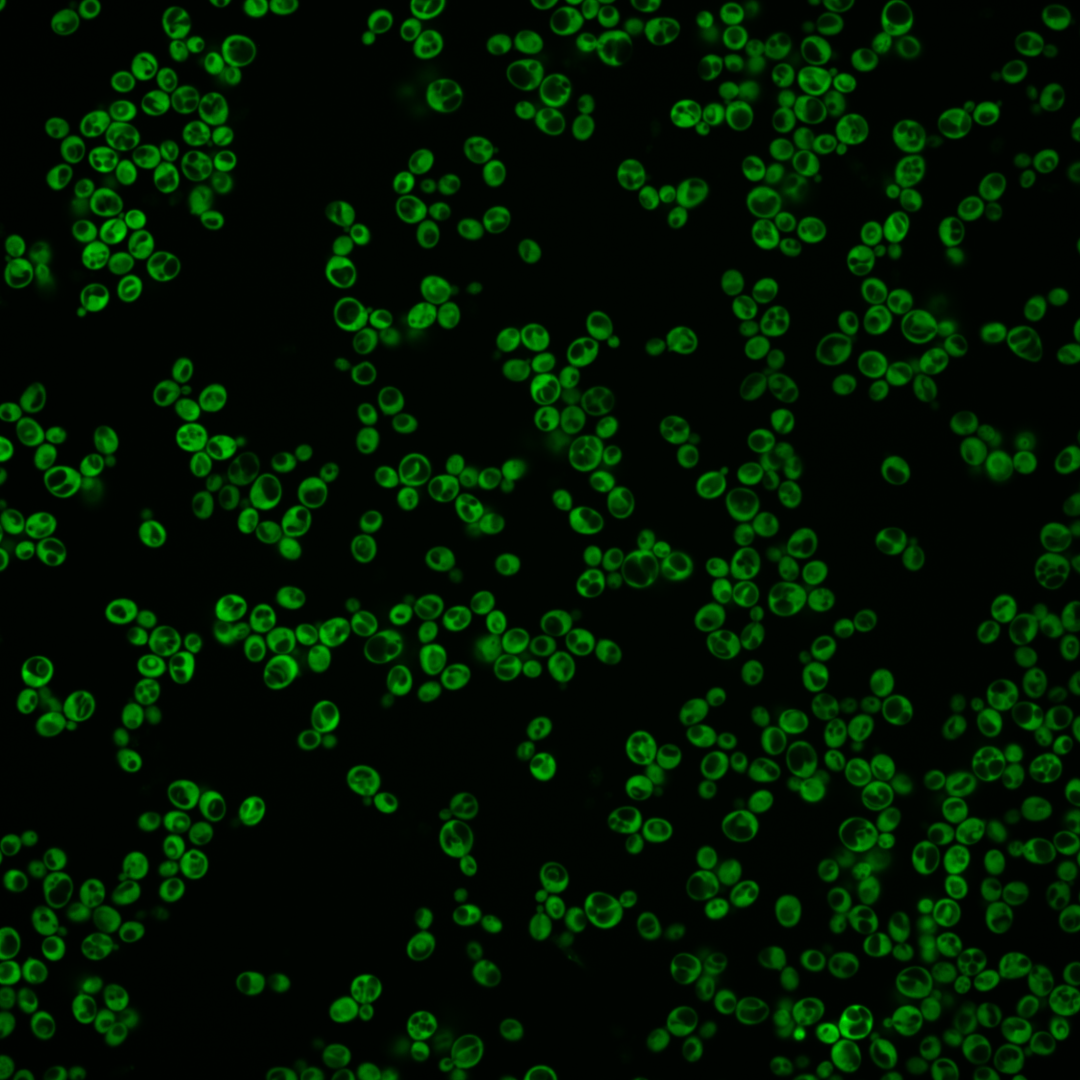
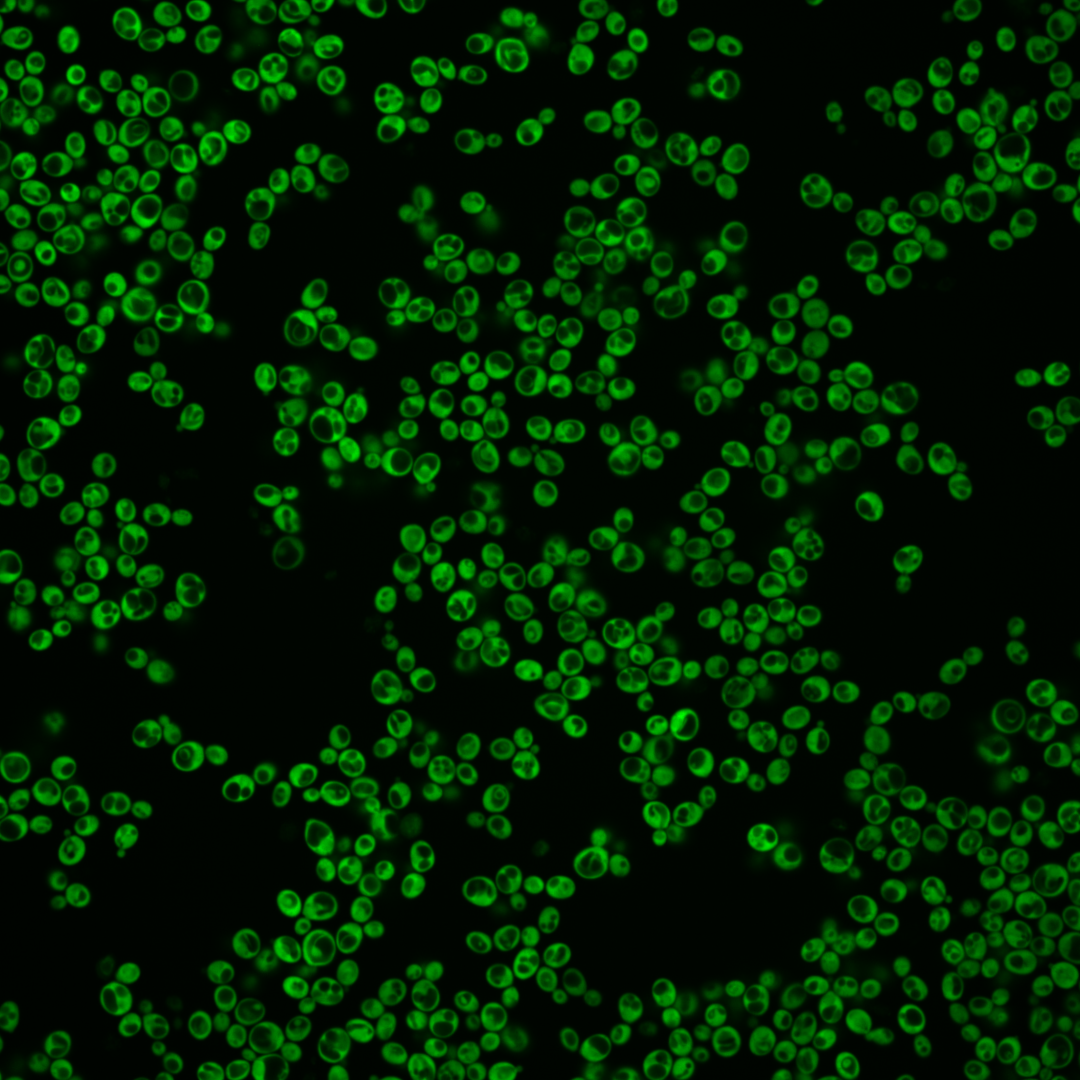
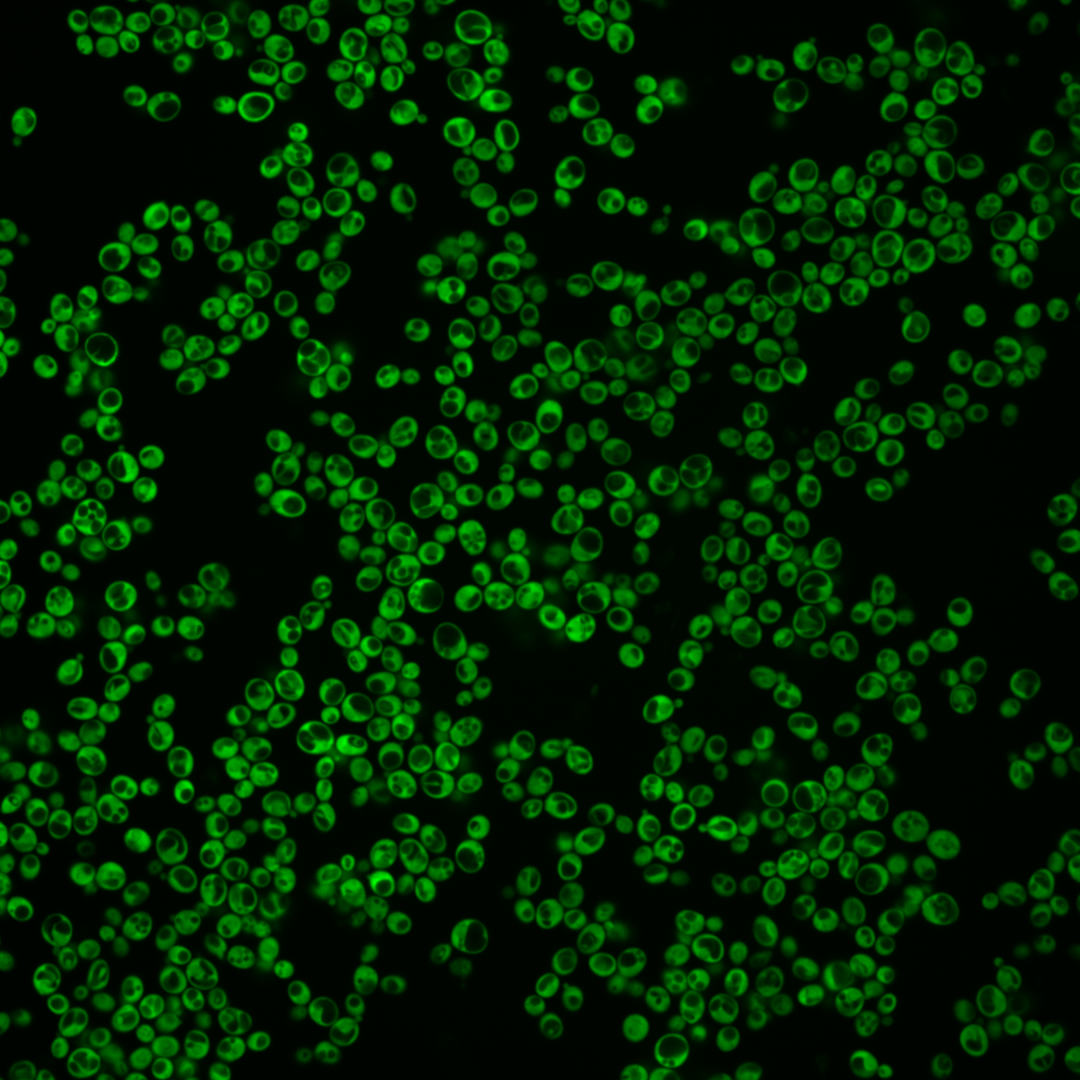
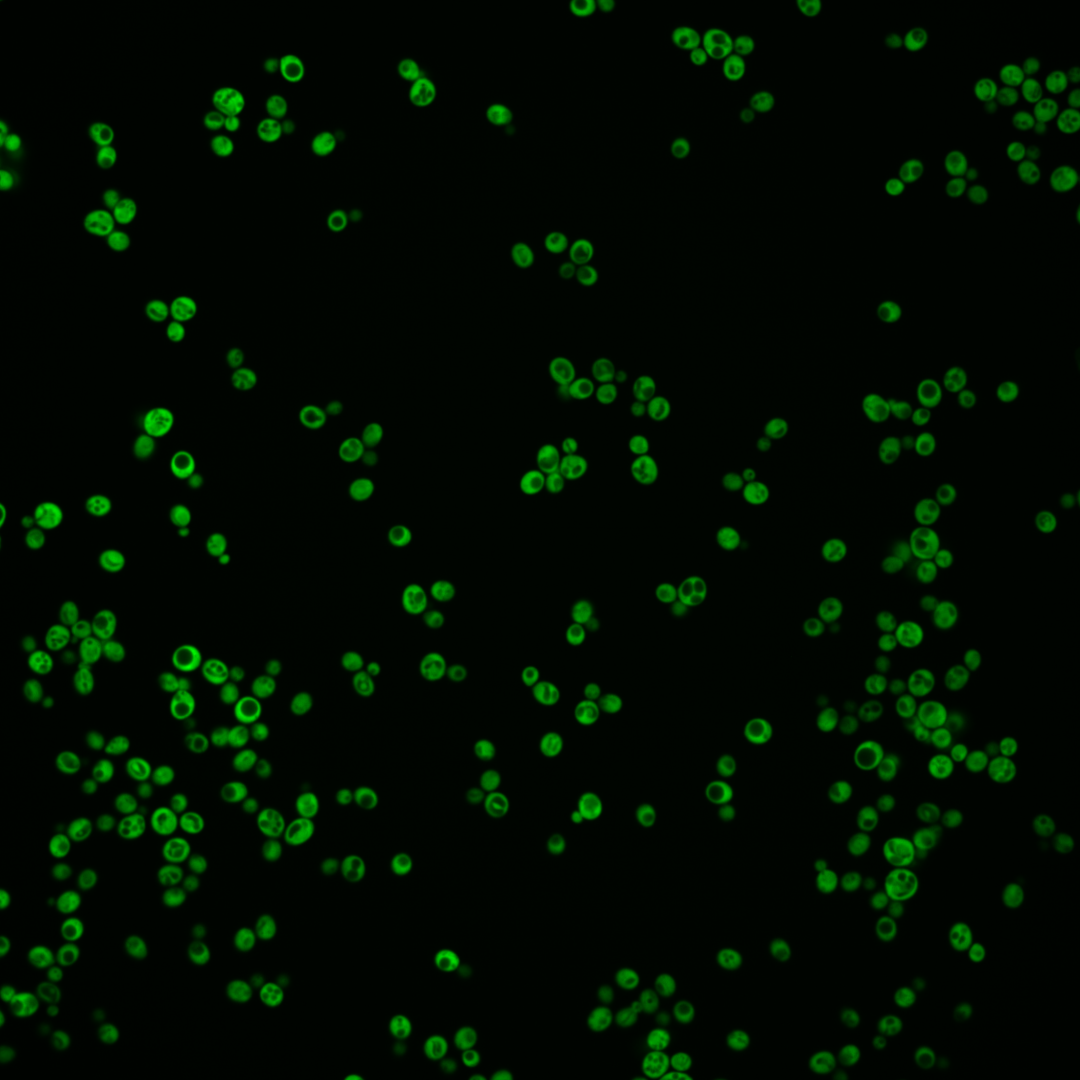
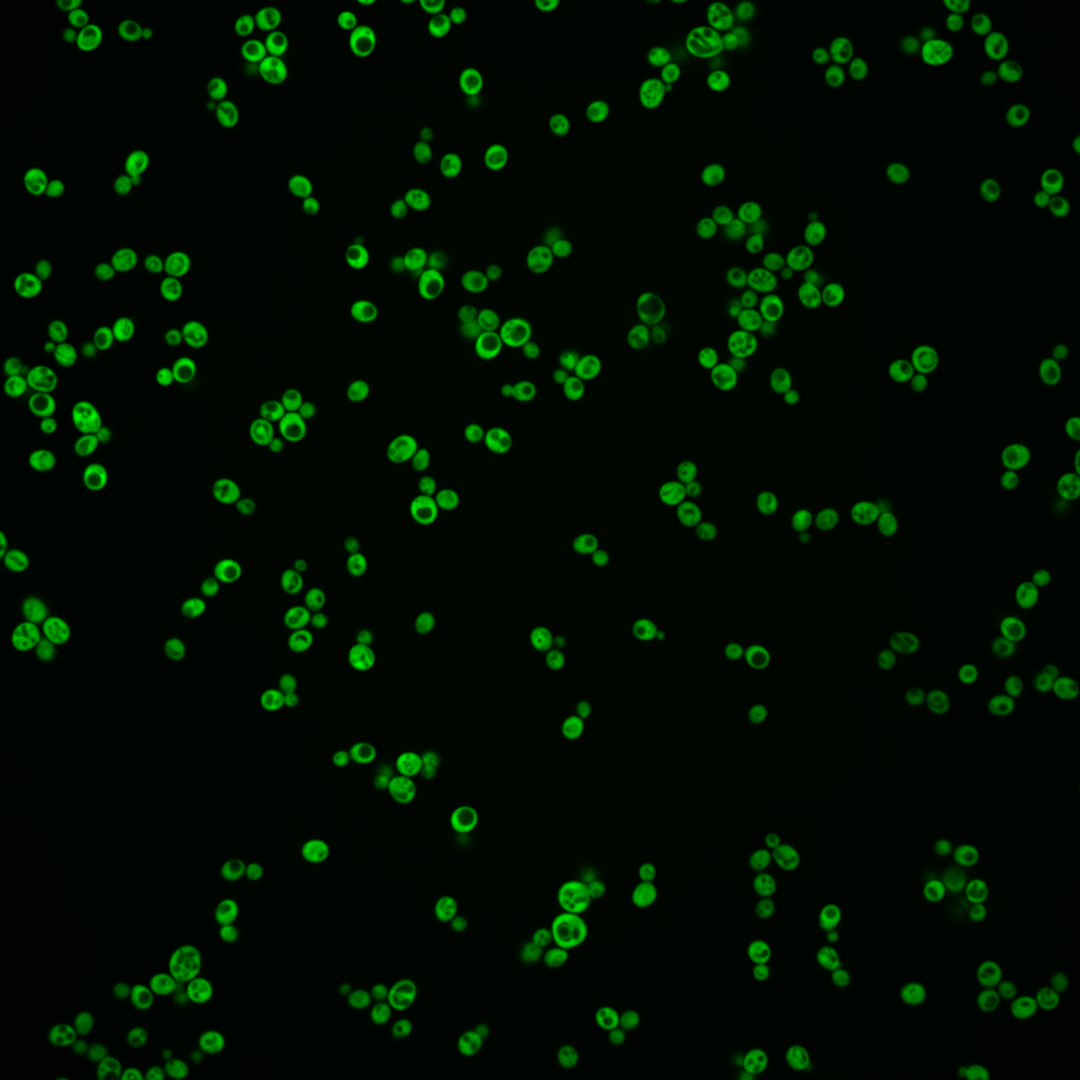
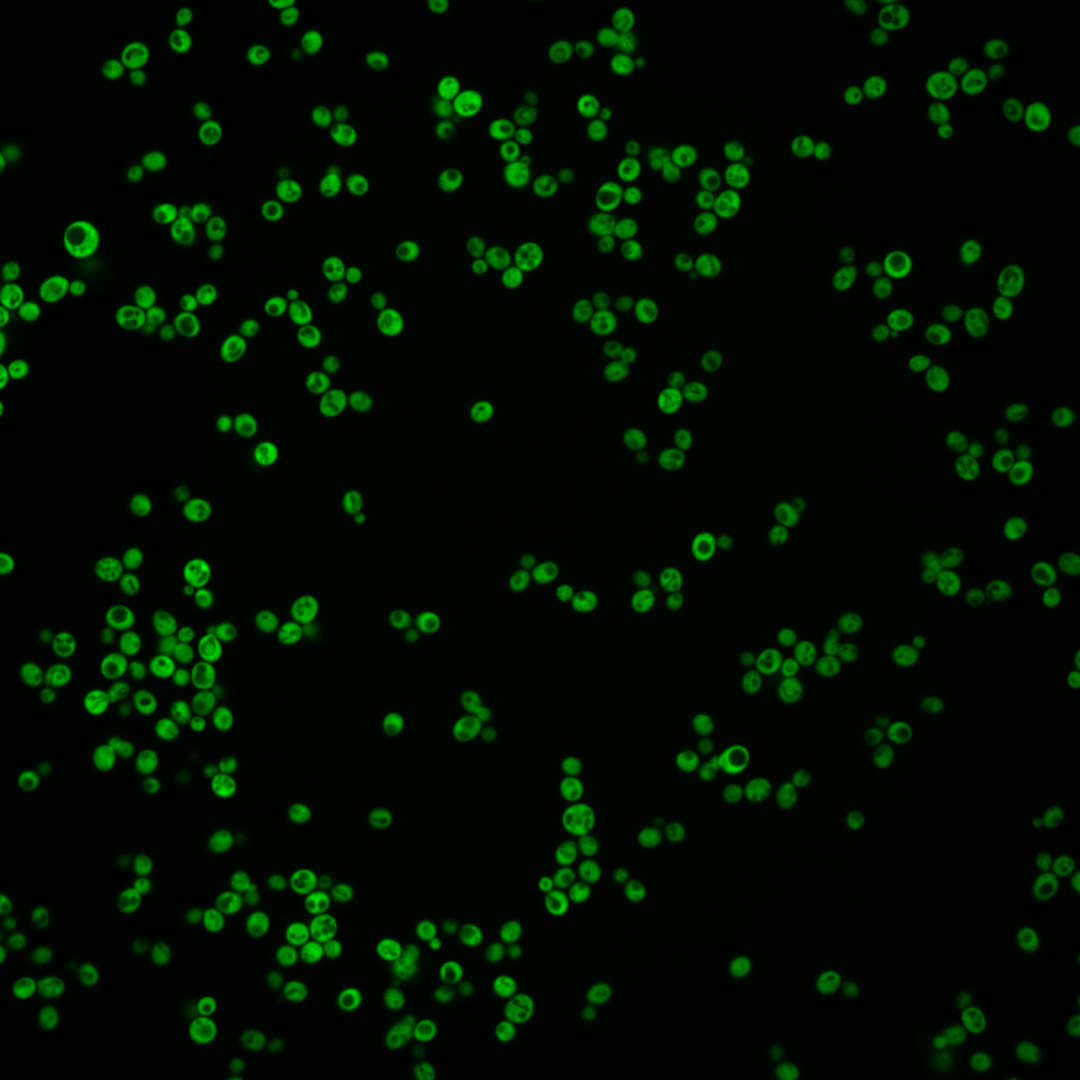

| Standard name | |
|---|---|
| Human Ortholog | |
| Description | Aromatic aminotransferase I; expression is regulated by general control of amino acid biosynthesis |
Micrographs




















































































Sub-cellular Localization
Yeast GFP Assignment
Protein Abundance
Localization Change
External localization resources
| ensLOC | DeepLoc | |||||||||||||||||||||||
|---|---|---|---|---|---|---|---|---|---|---|---|---|---|---|---|---|---|---|---|---|---|---|---|---|
| Localization | WT1 | WT2 | WT3 | RAP60 | RAP140 | RAP220 | RAP300 | RAP380 | RAP460 | RAP540 | RAP620 | RAP700 | HU80 | HU120 | HU160 | rpd3Δ_1 | rpd3Δ_2 | rpd3Δ_3 | WT1 | WT2 | WT3 | AF100 | AF140 | AF180 |
| Cortical Patches | 0 | 0 | 0 | 0 | 0 | 0 | 1 | 1 | 4 | 7 | 3 | 9 | 0 | 0 | 0 | 0 | 0 | 0 | 0 | 0 | 0 | 1 | 0 | 1 |
| Bud | 3 | 2 | 1 | 0 | 0 | 1 | 1 | 2 | 0 | 1 | 0 | 1 | 0 | 0 | 0 | 2 | 0 | 0 | 3 | 1 | 0 | 0 | 0 | 2 |
| Bud Neck | 0 | 0 | 0 | 0 | 0 | 0 | 0 | 0 | 0 | 0 | 0 | 0 | 0 | 0 | 0 | 0 | 0 | 0 | 0 | 0 | 0 | 0 | 0 | 0 |
| Bud Site | 0 | 0 | 0 | 0 | 0 | 0 | 0 | 0 | 0 | 0 | 0 | 0 | 0 | 0 | 0 | 0 | 0 | 0 | – | – | – | – | – | – |
| Cell Periphery | 0 | 3 | 5 | 3 | 1 | 3 | 19 | 13 | 13 | 15 | 18 | 29 | 5 | 4 | 5 | 5 | 6 | 3 | 0 | 0 | 0 | 0 | 0 | 0 |
| Cytoplasm | 277 | 337 | 204 | 203 | 241 | 305 | 358 | 321 | 249 | 276 | 199 | 239 | 207 | 334 | 427 | 228 | 187 | 188 | 252 | 328 | 183 | 108 | 155 | 180 |
| Endoplasmic Reticulum | 0 | 1 | 0 | 2 | 2 | 2 | 18 | 29 | 16 | 25 | 18 | 15 | 1 | 2 | 3 | 5 | 13 | 16 | 0 | 1 | 2 | 1 | 0 | 4 |
| Endosome | 0 | 0 | 0 | 0 | 0 | 0 | 0 | 0 | 0 | 0 | 0 | 0 | 0 | 0 | 0 | 0 | 0 | 0 | 0 | 0 | 0 | 0 | 0 | 2 |
| Golgi | 0 | 0 | 0 | 0 | 0 | 0 | 0 | 1 | 2 | 0 | 2 | 1 | 0 | 0 | 0 | 0 | 0 | 0 | 0 | 0 | 0 | 0 | 0 | 2 |
| Mitochondria | 0 | 0 | 0 | 0 | 0 | 0 | 1 | 0 | 5 | 2 | 3 | 7 | 0 | 0 | 0 | 0 | 1 | 0 | 0 | 0 | 0 | 1 | 0 | 1 |
| Nucleus | 0 | 0 | 0 | 0 | 1 | 1 | 0 | 0 | 0 | 0 | 1 | 0 | 0 | 0 | 1 | 1 | 0 | 0 | 0 | 0 | 0 | 0 | 1 | 1 |
| Nuclear Periphery | 0 | 0 | 0 | 0 | 0 | 0 | 0 | 0 | 0 | 0 | 0 | 1 | 0 | 0 | 0 | 0 | 0 | 0 | 0 | 0 | 1 | 0 | 0 | 0 |
| Nucleolus | 0 | 0 | 0 | 0 | 0 | 0 | 0 | 2 | 0 | 0 | 0 | 0 | 0 | 0 | 0 | 0 | 0 | 0 | 0 | 0 | 0 | 0 | 0 | 0 |
| Peroxisomes | 0 | 0 | 0 | 0 | 0 | 0 | 0 | 0 | 0 | 0 | 0 | 0 | 0 | 0 | 0 | 0 | 0 | 0 | 0 | 0 | 0 | 0 | 0 | 0 |
| SpindlePole | 0 | 0 | 0 | 0 | 0 | 0 | 0 | 0 | 0 | 0 | 0 | 0 | 0 | 0 | 0 | 0 | 0 | 0 | 0 | 0 | 0 | 0 | 0 | 0 |
| Vac/Vac Membrane | 0 | 2 | 0 | 0 | 0 | 0 | 0 | 1 | 0 | 1 | 1 | 2 | 1 | 0 | 0 | 0 | 4 | 2 | 0 | 1 | 1 | 0 | 1 | 3 |
| Unique Cell Count | 277 | 342 | 204 | 205 | 243 | 311 | 385 | 360 | 276 | 309 | 231 | 277 | 208 | 336 | 432 | 231 | 191 | 189 | 261 | 339 | 192 | 116 | 164 | 206 |
| Labelled Cell Count | 280 | 345 | 210 | 208 | 245 | 312 | 398 | 370 | 289 | 327 | 245 | 304 | 214 | 340 | 436 | 241 | 211 | 209 | 261 | 339 | 192 | 116 | 164 | 206 |
Yeast GFP Assignment
Protein Abundance
| Screen | WT1 | WT2 | WT3 | RAP60 | RAP140 | RAP220 | RAP300 | RAP380 | RAP460 | RAP540 | RAP620 | RAP700 | HU80 | HU120 | HU160 | rpd3Δ_1 | rpd3Δ_2 | rpd3Δ_3 | AF100 | AF140 | AF180 |
|---|---|---|---|---|---|---|---|---|---|---|---|---|---|---|---|---|---|---|---|---|---|
| Mean Cell GFP Intensity (1e-4) | 121.0 | 133.5 | 123.9 | 118.1 | 109.7 | 86.4 | 74.4 | 62.3 | 57.9 | 53.6 | 49.8 | 46.8 | 111.4 | 111.0 | 107.7 | 111.5 | 127.1 | 134.9 | 89.6 | 98.1 | 101.2 |
| Std Deviation (1e-4) | 28.8 | 30.6 | 31.2 | 28.7 | 21.5 | 22.9 | 18.8 | 18.1 | 16.3 | 14.4 | 13.8 | 13.9 | 23.1 | 25.5 | 22.4 | 28.8 | 45.3 | 36.4 | 29.3 | 26.7 | 36.4 |
| Intensity Change (Log2) | – | – | – | -0.07 | -0.18 | -0.52 | -0.74 | -0.99 | -1.1 | -1.21 | -1.32 | -1.41 | -0.15 | -0.16 | -0.2 | -0.15 | 0.04 | 0.12 | -0.47 | -0.34 | -0.29 |
Localization Change
| Localization | RAP60 | RAP140 | RAP220 | RAP300 | RAP380 | RAP460 | RAP540 | RAP620 | RAP700 | HU80 | HU120 | HU160 | rpd3Δ_1 | rpd3Δ_2 | rpd3Δ_3 |
|---|---|---|---|---|---|---|---|---|---|---|---|---|---|---|---|
| Cortical Patches | 0 | 0 | 0 | 0 | 0 | 0 | 0 | 0 | 0 | 0 | 0 | 0 | 0 | 0 | 0 |
| Bud | 0 | 0 | 0 | 0 | 0 | 0 | 0 | 0 | 0 | 0 | 0 | 0 | 0 | 0 | 0 |
| Bud Neck | 0 | 0 | 0 | 0 | 0 | 0 | 0 | 0 | 0 | 0 | 0 | 0 | 0 | 0 | 0 |
| Bud Site | 0 | 0 | 0 | 0 | 0 | 0 | 0 | 0 | 0 | 0 | 0 | 0 | 0 | 0 | 0 |
| Cell Periphery | 0 | 0 | 0 | 1.5 | 0.8 | 1.3 | 1.4 | 2.5 | 3.4 | 0 | 0 | 0 | 0 | 0.4 | 0 |
| Cytoplasm | -1.4 | -1.3 | -2.0 | -3.9 | -4.9 | -4.6 | -4.8 | -5.5 | -5.5 | -1.0 | -1.1 | -1.5 | -1.6 | -2.1 | -1.0 |
| Endoplasmic Reticulum | 0 | 0 | 0 | 3.1 | 4.2 | 3.5 | 4.2 | 4.1 | 3.4 | 0 | 0 | 0 | 0 | 3.8 | 4.2 |
| Endosome | 0 | 0 | 0 | 0 | 0 | 0 | 0 | 0 | 0 | 0 | 0 | 0 | 0 | 0 | 0 |
| Golgi | 0 | 0 | 0 | 0 | 0 | 0 | 0 | 0 | 0 | 0 | 0 | 0 | 0 | 0 | 0 |
| Mitochondria | 0 | 0 | 0 | 0 | 0 | 0 | 0 | 0 | 0 | 0 | 0 | 0 | 0 | 0 | 0 |
| Nucleus | 0 | 0 | 0 | 0 | 0 | 0 | 0 | 0 | 0 | 0 | 0 | 0 | 0 | 0 | 0 |
| Nuclear Periphery | 0 | 0 | 0 | 0 | 0 | 0 | 0 | 0 | 0 | 0 | 0 | 0 | 0 | 0 | 0 |
| Nucleolus | 0 | 0 | 0 | 0 | 0 | 0 | 0 | 0 | 0 | 0 | 0 | 0 | 0 | 0 | 0 |
| Peroxisomes | 0 | 0 | 0 | 0 | 0 | 0 | 0 | 0 | 0 | 0 | 0 | 0 | 0 | 0 | 0 |
| SpindlePole | 0 | 0 | 0 | 0 | 0 | 0 | 0 | 0 | 0 | 0 | 0 | 0 | 0 | 0 | 0 |
| Vacuole | 0 | 0 | 0 | 0 | 0 | 0 | 0 | 0 | 0 | 0 | 0 | 0 | 0 | 0 | 0 |
External localization resources
Images






























Protein Concentration and Protein Localization Data
| R1 | R2 | R3 | ||||||||||||||||
|---|---|---|---|---|---|---|---|---|---|---|---|---|---|---|---|---|---|---|
| G1 Pre-START | G1 Post-START | S/G2 | Metaphase | Anaphase | Telophase | G1 Pre-START | G1 Post-START | S/G2 | Metaphase | Anaphase | Telophase | G1 Pre-START | G1 Post-START | S/G2 | Metaphase | Anaphase | Telophase | |
| Concentration | 86.4671 | 111.1547 | 96.209 | 92.4528 | 90.5761 | 91.499 | 85.9906 | 112.8638 | 102.3994 | 99.7049 | 88.3674 | 103.8023 | 94.1842 | 115.6322 | 106.0941 | 96.3593 | 103.1707 | 105.7636 |
| Actin | 0.0122 | 0.0001 | 0.0083 | 0.0001 | 0.0003 | 0.0014 | 0.0279 | 0.0002 | 0.0043 | 0.0001 | 0.0008 | 0.0001 | 0.0071 | 0.0001 | 0.0002 | 0.0034 | 0.0003 | 0.0005 |
| Bud | 0.0016 | 0 | 0.0001 | 0.0004 | 0 | 0.0011 | 0.0007 | 0 | 0.0006 | 0.0001 | 0.0089 | 0.0001 | 0.0008 | 0 | 0.0002 | 0.0001 | 0.0001 | 0.0003 |
| Bud Neck | 0.0007 | 0.0001 | 0.0029 | 0.0004 | 0.0003 | 0.0021 | 0.0057 | 0.0002 | 0.0002 | 0.0002 | 0.0009 | 0.0004 | 0.0003 | 0.0001 | 0.0002 | 0.0002 | 0.0002 | 0.0008 |
| Bud Periphery | 0.0011 | 0 | 0.0001 | 0.0001 | 0 | 0.0019 | 0.0007 | 0 | 0.0008 | 0.0001 | 0.0046 | 0 | 0.0007 | 0 | 0.0002 | 0.0002 | 0 | 0.0001 |
| Bud Site | 0.0008 | 0 | 0.0021 | 0 | 0.0001 | 0.0029 | 0.002 | 0 | 0.0005 | 0 | 0.0009 | 0 | 0.0007 | 0 | 0.0002 | 0.0003 | 0.0001 | 0 |
| Cell Periphery | 0.003 | 0.0002 | 0.0003 | 0.0001 | 0.0001 | 0.0013 | 0.0017 | 0 | 0.0005 | 0.0003 | 0.0012 | 0 | 0.0003 | 0.0001 | 0.0007 | 0.0007 | 0.0001 | 0.0001 |
| Cytoplasm | 0.9165 | 0.997 | 0.9606 | 0.9819 | 0.9108 | 0.8882 | 0.8769 | 0.9976 | 0.9659 | 0.9641 | 0.9057 | 0.9972 | 0.9474 | 0.9982 | 0.9815 | 0.9237 | 0.9471 | 0.9938 |
| Cytoplasmic Foci | 0.0058 | 0.0001 | 0.0029 | 0.0004 | 0.0201 | 0.0072 | 0.0117 | 0.0001 | 0.0049 | 0.004 | 0.0073 | 0.0003 | 0.0051 | 0.0001 | 0.0017 | 0.0051 | 0.0274 | 0.0005 |
| Eisosomes | 0.0003 | 0 | 0.0002 | 0 | 0 | 0.0001 | 0.0005 | 0 | 0.0001 | 0.0001 | 0 | 0 | 0.0001 | 0 | 0 | 0.0005 | 0.0001 | 0 |
| Endoplasmic Reticulum | 0.0033 | 0.0002 | 0.0003 | 0.0002 | 0.0004 | 0.005 | 0.0033 | 0.0001 | 0.0018 | 0.0001 | 0.0003 | 0.0001 | 0.0009 | 0.0001 | 0.0001 | 0.001 | 0.0003 | 0.0005 |
| Endosome | 0.0043 | 0 | 0.0003 | 0.0002 | 0.0008 | 0.0017 | 0.0066 | 0 | 0.0009 | 0.0001 | 0.0019 | 0 | 0.0031 | 0 | 0.0001 | 0.0048 | 0.0008 | 0.0001 |
| Golgi | 0.0007 | 0 | 0.0007 | 0 | 0.001 | 0.0004 | 0.0027 | 0 | 0.0003 | 0 | 0.0003 | 0 | 0.0013 | 0 | 0.0001 | 0.0014 | 0.0003 | 0 |
| Lipid Particles | 0.0015 | 0 | 0.0009 | 0 | 0.0133 | 0.0035 | 0.0041 | 0 | 0.0014 | 0.0012 | 0.0026 | 0 | 0.0046 | 0 | 0.0006 | 0.0103 | 0.0057 | 0 |
| Mitochondria | 0.0042 | 0 | 0.0015 | 0.0002 | 0.0027 | 0.008 | 0.0048 | 0 | 0.0053 | 0.0136 | 0.0085 | 0 | 0.0026 | 0 | 0.0053 | 0.0068 | 0.0018 | 0.0001 |
| None | 0.0054 | 0 | 0.0025 | 0.0004 | 0.0016 | 0.0017 | 0.0112 | 0.0001 | 0.0035 | 0.0022 | 0.0056 | 0.0001 | 0.0035 | 0.0001 | 0.0031 | 0.0049 | 0.0044 | 0.0002 |
| Nuclear Periphery | 0.0056 | 0.0005 | 0.0013 | 0.001 | 0.0016 | 0.0042 | 0.0099 | 0.0005 | 0.0011 | 0.0003 | 0.0016 | 0.0003 | 0.0025 | 0.0002 | 0.0003 | 0.0046 | 0.0007 | 0.0006 |
| Nucleolus | 0.0054 | 0 | 0.0066 | 0.0003 | 0.0014 | 0.0265 | 0.0054 | 0 | 0.0018 | 0.0079 | 0.0077 | 0 | 0.0031 | 0 | 0.0008 | 0.0161 | 0.0029 | 0 |
| Nucleus | 0.0161 | 0.0013 | 0.0042 | 0.0046 | 0.0039 | 0.0297 | 0.0075 | 0.0009 | 0.0022 | 0.002 | 0.0055 | 0.0012 | 0.0076 | 0.0009 | 0.0017 | 0.0073 | 0.0021 | 0.0021 |
| Peroxisomes | 0.0003 | 0 | 0.0009 | 0 | 0.0376 | 0.0006 | 0.0014 | 0 | 0.0003 | 0.0008 | 0.0006 | 0 | 0.0011 | 0 | 0.0015 | 0.002 | 0.0007 | 0 |
| Punctate Nuclear | 0.0008 | 0 | 0.0004 | 0.0001 | 0.0025 | 0.002 | 0.002 | 0 | 0.0003 | 0.0001 | 0.0003 | 0 | 0.0013 | 0 | 0.0001 | 0.0028 | 0.0037 | 0 |
| Vacuole | 0.0078 | 0.0003 | 0.0017 | 0.0072 | 0.0011 | 0.0073 | 0.0098 | 0.0002 | 0.0022 | 0.0013 | 0.017 | 0.0001 | 0.0038 | 0.0002 | 0.0012 | 0.0015 | 0.0006 | 0.0003 |
| Vacuole Periphery | 0.0025 | 0 | 0.001 | 0.0025 | 0.0006 | 0.0029 | 0.0035 | 0 | 0.0011 | 0.0014 | 0.0179 | 0 | 0.0019 | 0 | 0.0002 | 0.0022 | 0.0005 | 0.0001 |
Sequencing Data
| R1 | R2 | |||||||||
|---|---|---|---|---|---|---|---|---|---|---|
| G1 Post-START | S/G2 | Metaphase | Anaphase | Telophase | G1 Post-START | S/G2 | Metaphase | Anaphase | Telophase | |
| Gene Expression | 315.6779 | 301.2287 | 309.2335 | 310.5516 | 285.5513 | 321.373 | 301.2542 | 305.2134 | 300.1694 | 293.5076 |
| Translational Efficiency | 1.3341 | 1.3618 | 1.245 | 1.2814 | 1.3693 | 1.3089 | 1.3872 | 1.1208 | 1.1708 | 1.1678 |
Hit Data
| Dataset | Hit |
|---|---|
| Protein Concentration | ✘ |
| Protein Localization | ✘ |
| Gene Expression | ✘ |
| Translational Efficiency | ✘ |
Endocytosis
| Temp | Actin Patch (Sac6-tdTomato) | Cortical Patch (Sla1-GFP) | Late Endosome (Snf7-GFP) | Vacuole (Vph1-GFP) |
|---|---|---|---|---|
| 37℃ | ||||
| RT |
Cell Cycle Omics
CYCLoPs (Aro8-GFP)
| Gene / Allele | Actin Patch (Sac6-tdTomato) | Cortical Patch (Sla1-GFP) | Late Endosome (Snf7-GFP) | Vacuole (Sac6-tdTomato) |
|---|
| Gene | Images |
|---|
| Gene | Images |
|---|
Images are not yet available
Images are not yet available